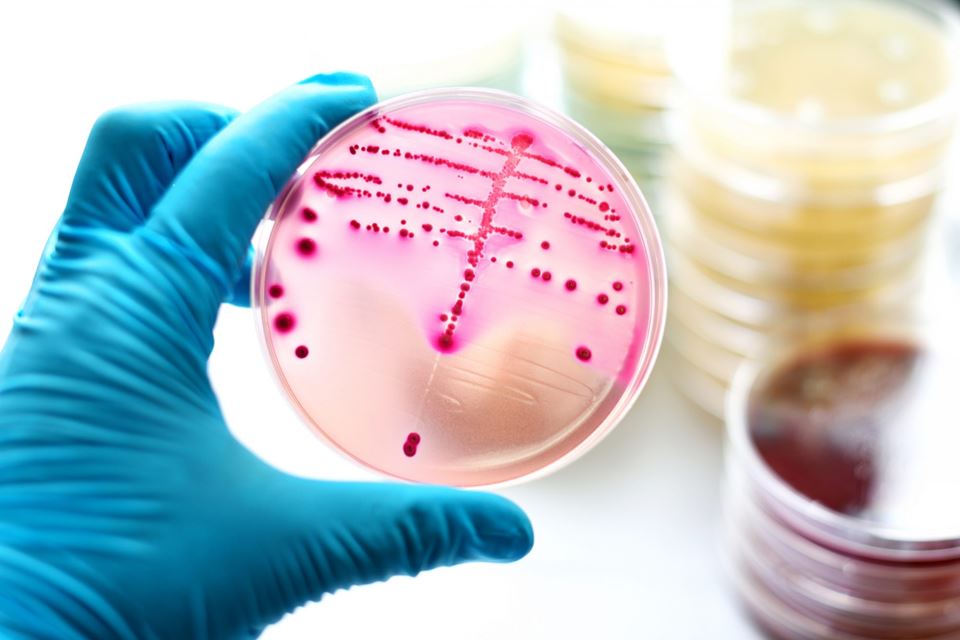

Bakterier er over alt. De vokser på huden og i tarmene, og er nesten like mange som menneskecellene i en kropp. Bakteriene kan også leve på bunnen av havet, overleve tiår nedfrosset i isen, og dypt under bakken. De har gjort det i millioner av år, og kommer til å gjøre det lenge etter at menneskene er borte.
Stort sett har bakteriene et dårlig rykte, og symboliserer sykdom, død og forråtnelse. De deler seg ustoppelig, spiser i vei på hud, tre og metall, og utvikler forsvarsmekanismer mot medisinske oppdagelser. Samtidig har bakterier og medisin en lang historie bygget på samarbeid. I tiår har forskere utnyttet bakterienes talenter. Nå har duoen fått en tredje partner: datamaskiner.
Lenke til prosjekter
Flytter grenser med digitale modeller
Digitale, matematiske modeller har åpnet et hav av muligheter for bioteknologi, og ambisiøse forskere flytter grensene for hva bakterier kan få til.
– Vi vil bruke bakterier til å lage sement, sier Anja Røyne ved Fysisk institutt på Universitetet i Oslo (UiO), prosjektleder for BioZEment 2.0.
Resultatet: en fast klump med sement, laget av bakterier.
Røyne beskriver en fremtid der bakteriene lager konstruksjonsmateriale til bygninger og infrastruktur. Hun har selv en bakgrunn fra fysikk, og håper å løse et stort problem innen industriell produksjon av sement: store klimautslipp fra fabrikkene som brenner kalkstein for å få tak reaktive råmaterialer til sementproduksjonen.
Klarer Røyne å få bakteriene til å gjøre det samme, uten utslipp av CO2?
Sammen med et stort team av forskere håper hun å få to grupper av bakterier til å samarbeide om jobben. Den første gruppen av mikroorganismer bader i et sukkerrikt substrat mens de deler opp kalksteinen til kalsium og karbonat. En annen gruppe bakterier bruker den oppløste kalksteinen til å lime sammen sandkorn. Resultatet: en fast klump med sement, laget av bakterier.
Nyhet: Digitale bakterier
– De første resultatene var ikke strålende, og jeg ville ikke ha bygget et hus av den første sementen fra laboratoriet. Men eksperimentene viser at prosessen kan fungere, kommenterer Røyne.
Et første steg er å arbeide med digitale bakterier for å kartlegge fysikken og kjemien bak bakterienes egenskaper.
Finansiering fra Digitalt Liv Norge (DLN) lar forskerne utforske og forme den levende produksjonsenheten. Et første steg er å arbeide med digitale bakterier for å kartlegge fysikken og kjemien bak bakterienes egenskaper.
– Vi utvikler nå to modeller. Den ene er for å teste hvordan bakterier, næringsstoffer, vann og sandkorn oppfører seg i liten skala. Den andre modellen inneholder de genetiske og metabolske prosessene i bakteriene, forklarer Røyne.

Forsker Alexander Wentzel bruker digitale bakterier i jakten på en ny type antibiotika, for å nevne noe. Foto: SINTEF
Alexander Wentzel er en viktig samarbeidspartner i prosjektet, og arbeider på SINTEF i Trondheim. Regionen har også bidratt med lokale bakterier til prosjektet.
– Vi trengte bakterier som ville tåle å leve i et miljø med høy pH, så jeg reiste på en liten ekspedisjon i nærheten av et kalksteinsbrudd for å samle inn prøver. I jordprøvene fant vi bakterier som kan bidra til sementproduksjonen, forklarer Wentzel.
Har tusenvis av bakterier i samlinga
En annen, og langt større bakterieinnhøsting kommer fra fjorden utenfor Trondheim, og SINTEF sin nåværende samling inneholder flere tusen marine bakterier. For 1200 av bakteriene har forskerne kartlagt det genetiske arvematerialet.
Wentzel og kollegaene hans vil bruke dataene for å oppdage nye antibiotika, et DLN-prosjekt kalt INBioPharm. Ved å kartlegge potensielle gener fra bakteriene ved hjelp av matematiske modeller, og så teste genene i vertsbakterier på laboratoriet, håpar Wentzel å gjøre oppdagelser som er relevante for farmasøytisk industri.
– Vi lager også bioinformatiske verktøy som er verdifulle for andre prosjekter, kommenterer han.
Å kombinere matematiske modeller og eksperimentelt arbeid for å oppdage interessante gener og biomolekyler er relevant for prosjekter innen helse, industri og landbruk.
…og enzymer
Biokjemiker Vincent Eijsink ved NMBU på Ås er ikke primært interessert i antibiotika, men i bakterielle enzymer.
– Vårt mål er å kombinere digitale modeller med laboratorieeksperiment for å oppdage hvordan spesialiserte bakterieenzymer arbeider sammen for å bryte ned plantemateriale, sier Eijsink.
– Enzymene kan gjøre jobben for oss, og bakteriene viser oss hvordan.
I DLN-prosjektet OXYMOD er målet å oppdage og utvikle enzymer som kan omforme biomasse fra avfall til nyttige produkter. Både OXYMOD og INBioPharm baserer seg på data fra de marine bakteriene, men forskerne bruker ulike detaljerte algoritmer og databaser for å identifisere interessante gener og enzymer.
Prosjektet på NMBU har nylig startet opp, og Eijsink estimerer at det vil ta et par år å få modellene på plass. Da kan han og kollegaene hans begynne å modifisere både digitale og levende bakterier, og optimalisere systemene som trengs for å prosessere biomassen.
– Målet er å resirkulere og raffinere plantemateriale fra skogbruk og landbruk til brukbare produkter. Enzymene kan gjøre jobben for oss, og bakteriene viser oss hvordan, sier Eijsink.
Trekker til seg gull
En annen jobb som bakteriene enkelt kan utføre er å ta opp metaller fra omgivelsene.
– De tar opp palladium eller gull fra omgivelsene sine og redusere metallene til nanopartikler, forklarer Dirk Linke ved Institutt for biovitenskap på UiO.
Han og kollegaene hans kartlegger hvordan bakterier med tilfeldige mutasjoner utfører denne oppgaven. De ørsmå partiklene fra bakteriene har ofte interessante katalytiske egenskaper, og kan for eksempel brukes i oljeindustrien. Målet med Linkes DLN-prosjekt er å modifisere og finjustere bakteriene slik at de lager nye og potensielt nyttige nanopartikler.
– Det dukker kanskje opp nye og interessante egenskaper ved nanopartiklene når vi kan justere størrelse og sammensetning, og kombinere ulike metaller for å lage nanopartikler med spesifikke bruksområder, sier han.
Mellom benken og skjermen
På laboratoriet tester Linke og kollegaene hans hvordan ulike grupper av bakterier kan ta opp, redusere og produsere nanopartikler. De eksperimentelle resultatene danner grunnlaget for digitale, matematiske modeller.
Linke, Røyne og Wentzel samarbeider med systembiolog Eivind Almaas ved Institutt for bioteknologi og matvitenskap på NTNU, en ekspert på å se sammenhenger mellom laboratorieeksperimenter og modellene.
– Systembiologi handler om å integrere eksperimentelle og digitale data for å hente ut mer og bedre kunnskap til forskningsprosjektene, sier Almaas.
Saken fortsetter under bildet.

Systembiolog Eivind Almaas på sitt kontor. Foto: Per Henning/NTNU
De interdisiplinære forskningsgruppene samarbeider tett, og bruker resultater fra de digitale modellene til å prioritere hvilke eksperimenter de bør utføre først. Det sparer forskerne tid og krefter, og hjelpen fra digitale verktøy kan også vise vei til andre retninger med potensiale for nye oppdagelser.
Integrert i hvert forskningsprosjekt er det åpne spørsmålet om hvordan bakteriene vil påvirke samfunnet i fremtiden. Andre utfordringer inkluderer størrelsen på de digitale modellene, hvordan gi nok næring til tallrike bakterier i industrielle inkubatorer, og hvordan håndtere de bioteknologiske reguleringene for genmodifiserte bakterier.
Digital livsvitenskap vil trenge mer enn datamaskiner for å møte disse utfordringene.
Gemini.no deler denne saken med nettstedene til samarbeidspartnerne ved UiO, NTNU og NMBU på Ås.